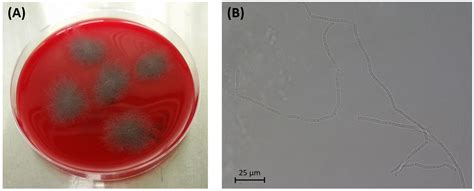

Bacillus Pseudomycoides: A Deep Dive
Bacillus Pseudomycoides: A Deep Dive
Hey everyone! Today, we’re diving deep into the fascinating world of Bacillus pseudomycoides . You might not have heard of it before, but trust me, this little microbe is pretty darn interesting and has some cool applications. We’re going to break down what it is, where it comes from, and why it matters. So grab a coffee, settle in, and let’s get our science on!
Table of Contents
Understanding Bacillus Pseudomycoides
So, what exactly is Bacillus pseudomycoides ? At its core, it’s a bacterium, belonging to the Bacillus genus. Now, the Bacillus genus is a pretty big deal in the microbiology world. You’ve probably heard of Bacillus subtilis or Bacillus cereus , right? Well, Bacillus pseudomycoides is a relative of these guys. It’s a Gram-positive, rod-shaped bacterium, and like many of its cousins, it’s known for its ability to form endospores. This spore-forming ability is a huge deal because it allows these bacteria to survive in some pretty harsh conditions – think extreme temperatures, radiation, and even a lack of nutrients. They can just chill out in their spore form until conditions improve, and then they spring back to life. Pretty neat, huh?
Discovery and Classification
Bacillus pseudomycoides was first described back in 1995. It was identified as a distinct species based on its unique genetic makeup and some subtle differences in its biochemical properties compared to other Bacillus species. You know how sometimes different breeds of dogs look similar but are totally different species? It’s kind of like that, but on a microbial level. Scientists use things like DNA sequencing (specifically, analyzing ribosomal RNA genes) and protein profiles to figure out how different bacteria are related. This meticulous work is how Bacillus pseudomycoides got its own spot on the microbial family tree. It’s usually found in soil and dust, which makes sense given its hardy nature. Think about the millions of tiny organisms living in the dirt under your feet – Bacillus pseudomycoides is one of them, working away in its own little world.
Key Characteristics
- Morphology: It’s a rod-shaped bacterium, typically about 0.5-1.5 micrometers wide and 2-10 micrometers long. So, we’re talking really tiny, you definitely need a microscope to see it. They often appear singly or in short chains. You might also see them moving around thanks to flagella, which are like tiny whip-like tails that help them swim.
- Gram Staining: As I mentioned, it’s Gram-positive. This is a crucial test in microbiology that helps classify bacteria based on their cell wall structure. Gram-positive bacteria have a thick peptidoglycan layer, which stains purple under a microscope. This is a fundamental characteristic used in identifying bacterial species.
- Endospore Formation: This is one of its most defining traits. Bacillus pseudomycoides can produce endospores, which are highly resistant structures that allow the bacterium to survive extreme environmental conditions. These spores can last for incredibly long periods, waiting for the right moment to germinate and grow into active cells again. This resilience is what makes Bacillus species so interesting from a survival perspective.
- Metabolism: It’s typically aerobic or facultative anaerobic, meaning it can grow with or without oxygen, although it prefers oxygen. It’s heterotrophic, meaning it needs organic compounds for energy. It’s a decomposer, breaking down organic matter in its environment, which is a vital role in ecosystems.
- Motility: It’s motile, meaning it can move around. This is usually due to the presence of flagella, which are hair-like appendages that propel the bacterium. This mobility helps it find nutrients and suitable environments.
So, when you put it all together, Bacillus pseudomycoides is a tough, resilient, rod-shaped bacterium commonly found in soil, playing its part in the grand cycle of decomposition. It’s a master of survival, thanks to those incredible endospores it can whip up. Pretty amazing stuff when you think about the sheer tenacity of life at this scale.
Where Does Bacillus Pseudomycoides Live?
Alright, so we know what Bacillus pseudomycoides is, but where does this little guy hang out? Think of it as a true creature of the earth – its primary habitat is soil . Yep, the dirt beneath your feet is teeming with Bacillus pseudomycoides and its countless microbial buddies. It thrives in various soil types, from agricultural fields to natural environments. It’s not picky, which is part of its success story. It’s essentially a soil dweller, a tiny organism that plays a significant role in the complex ecosystems found underground.
Environmental Niches
Beyond just general soil, Bacillus pseudomycoides has been found in a few other interesting places, often related to dusty or dry environments. You might find it in dust samples , which makes sense because soil particles get kicked up into the air. It’s also been isolated from plant roots and even insects , suggesting it can form associations with other organisms. It’s not necessarily a pathogen in these cases; often, it might be living commensally (meaning it benefits or at least doesn’t harm the host) or even symbiotically. Its ability to form those tough endospores means it can survive transport through these different environments without breaking a sweat. It’s like a tiny, microscopic nomad, adapting and surviving wherever it lands.
Soil Ecosystems
In the soil, Bacillus pseudomycoides contributes to the decomposition of organic matter. This is a crucial ecological function , guys! By breaking down dead plants and animals, it releases essential nutrients back into the soil, making them available for plants to use. This nutrient cycling is fundamental for healthy plant growth and, by extension, for the entire food web. So, while it’s just one bacterium among billions, its role in nutrient turnover is super important. It’s part of the underground workforce that keeps our planet healthy and productive. Without these decomposers, nutrients would get locked up in dead organic matter, and life as we know it wouldn’t be sustainable.
Potential for Bio-control
Interestingly, its presence in soil and its interactions with other microbes have led researchers to explore its potential as a bio-control agent . What does that mean? It means using a living organism to control pests or diseases, often in agriculture. Some strains of Bacillus pseudomycoides have shown the ability to suppress the growth of certain plant pathogens. This could offer a more natural and environmentally friendly alternative to chemical pesticides. Imagine using a beneficial bacterium to fight off harmful fungi or bacteria that attack crops! It’s a really exciting area of research, and Bacillus pseudomycoides is showing promise.
So, to sum it up, Bacillus pseudomycoides is a soil-loving bacterium that also pops up in dusty environments and can associate with plants and insects. Its main gig is breaking down organic stuff, but it’s also got potential as a helpful ally in agriculture. It’s a testament to how even the smallest organisms play vital roles in the world around us.
Applications and Research
Now, let’s talk about why Bacillus pseudomycoides is getting attention in the research world. While it might not be as famous as Bacillus thuringiensis (Bt), which is widely used as a bio-pesticide, Bacillus pseudomycoides has some unique properties that make it a subject of interest for various applications. We’re talking about everything from agriculture to potentially even human health, though more research is needed on that last front. It’s pretty cool to see how a humble soil bacterium can have such diverse potential uses.
Agricultural Potential
This is where Bacillus pseudomycoides is showing some of its most exciting promise, especially in the realm of sustainable agriculture . As we touched upon earlier, its ability to act as a bio-control agent is a big one. Certain strains have demonstrated the capacity to inhibit the growth of various plant pathogens, including fungi and other bacteria that can devastate crops. This means it could potentially be developed into a biological fungicide or bactericide. Instead of spraying harsh chemicals, farmers could use a natural microbial agent to protect their plants. How awesome is that? Plus, its role in plant growth promotion is also being investigated. Some Bacillus species are known to enhance plant growth by improving nutrient availability (like solubilizing phosphorus) or producing plant hormones. Bacillus pseudomycoides might do similar things, leading to healthier, more robust crops with potentially less need for synthetic fertilizers. It’s a win-win for the environment and for food production. Think of it as giving plants a friendly microbial boost to help them thrive naturally.
Probiotic Possibilities
This is a more speculative area, but it’s definitely worth mentioning. Some research has explored the probiotic potential of certain Bacillus species, and Bacillus pseudomycoides is no exception. Probiotics are live microorganisms that, when administered in adequate amounts, confer a health benefit on the host. Now, Bacillus bacteria are often considered good candidates for probiotics because, like Bacillus pseudomycoides , they can form those super-resilient endospores. This means they can survive the harsh acidic environment of the stomach and reach the intestines intact, where they can then germinate and exert their beneficial effects. While Bacillus subtilis is more commonly studied and used as a probiotic, Bacillus pseudomycoides shares many similar traits. Potential benefits could include improving gut health, modulating the immune system, and even producing antimicrobial substances that help combat harmful gut bacteria. However, it’s crucial to note that much more research is needed to confirm these effects and establish safety and efficacy in humans. We’re not talking about popping Bacillus pseudomycoides pills just yet, but the idea is there, and it’s exciting!
Industrial Enzymes
Bacillus species, in general, are workhorses in the biotechnology and industrial sectors because they are prolific producers of enzymes. Enzymes are biological catalysts that speed up chemical reactions, and they have tons of uses – from laundry detergents (think breaking down stains) to food processing and even biofuel production. While specific research on Bacillus pseudomycoides for large-scale enzyme production might be less extensive compared to its relatives like Bacillus licheniformis or Bacillus amyloliquefaciens , it’s highly probable that it possesses the genetic machinery to produce a range of useful enzymes. Future research could unlock its potential to churn out specific enzymes for industrial applications, contributing to greener and more efficient manufacturing processes.
Research Challenges and Future Directions
Despite its potential, research on Bacillus pseudomycoides still faces challenges. One hurdle is strain selection . Not all strains of a bacterium are created equal; some might have beneficial traits while others don’t. Identifying and isolating the specific strains with the desired properties (like potent bio-control activity or specific enzyme production) requires extensive screening. Another challenge is scaling up production . If a strain shows promise for agricultural or industrial use, developing cost-effective methods to grow large quantities of the bacteria is essential. Finally, for any potential probiotic application, rigorous clinical trials are a must to ensure safety and prove efficacy in humans. The future looks bright, though. As our understanding of microbial genomics and metabolomics grows, we’ll likely uncover even more about Bacillus pseudomycoides and its capabilities. Expect more research focusing on isolating superior strains, understanding its mechanisms of action in different environments, and developing practical applications.
In conclusion, Bacillus pseudomycoides is more than just a soil dweller. It’s a microbe with significant potential in agriculture, and possibly even in human health and industry. The ongoing research is uncovering its multifaceted capabilities, making it a bacterium worth keeping an eye on. It’s a great example of how much we still have to learn from the microbial world!
Conclusion: The Unsung Hero of the Soil
So, there you have it, guys! We’ve journeyed through the world of Bacillus pseudomycoides , from its humble beginnings in the soil to its exciting potential in agriculture and beyond. It’s easy to overlook these tiny organisms, but as we’ve seen, they play absolutely crucial roles in our ecosystems and hold promise for future innovations. Bacillus pseudomycoides might not be a household name, but it’s a testament to the power and diversity of microbial life.
We’ve learned that it’s a resilient, spore-forming bacterium, a master survivor found predominantly in soil, dust, and occasionally associated with plants and insects. Its primary ecological function as a decomposer is vital for nutrient cycling, keeping our planet healthy and productive. Without these hardworking microbes, life as we know it simply wouldn’t be possible. They are the unsung heroes of the soil, performing essential tasks that often go unnoticed.
Moreover, the research into its applications is truly inspiring. Its potential as a bio-control agent in agriculture could lead to more sustainable farming practices, reducing our reliance on harmful chemical pesticides. Imagine fields protected by beneficial bacteria – it’s a future that’s becoming more attainable thanks to microbes like Bacillus pseudomycoides . The possibility of it contributing to plant growth promotion further adds to its value in the agricultural sector, promising healthier crops and more efficient food production.
While the probiotic potential is still in its early stages and requires much more investigation, the inherent characteristics of Bacillus pseudomycoides – particularly its robust endospore formation – make it an interesting candidate for gut health applications. The fact that these spores can survive the journey through our digestive system is a significant advantage, opening doors for future therapeutic or health-promoting uses.
Furthermore, like many Bacillus species, it likely possesses the ability to produce industrial enzymes , offering possibilities for greener manufacturing processes and a wide range of biotechnological applications. The ongoing exploration of these capabilities highlights the immense untapped potential within this single species.
The journey of understanding Bacillus pseudomycoides is far from over. Future research will undoubtedly uncover more about its complex interactions within microbial communities, its specific metabolic pathways, and the precise mechanisms behind its beneficial effects. The development of advanced screening techniques and genomic analysis will help us identify and harness the most potent strains for specific applications. As we continue to unravel the secrets held within our soils and diverse environments, bacteria like Bacillus pseudomycoides will undoubtedly continue to surprise and benefit us.
So, the next time you walk on the earth, take a moment to appreciate the invisible world beneath your feet. It’s a bustling metropolis of microorganisms, each with its own role to play. Bacillus pseudomycoides is just one example, a tiny but mighty player in the grand theatre of life. It’s a reminder that even the smallest among us can have the biggest impact. Let’s give a round of applause for this amazing soil bacterium – a true unsung hero!
Keep exploring, keep learning, and remember the incredible power of microbes!